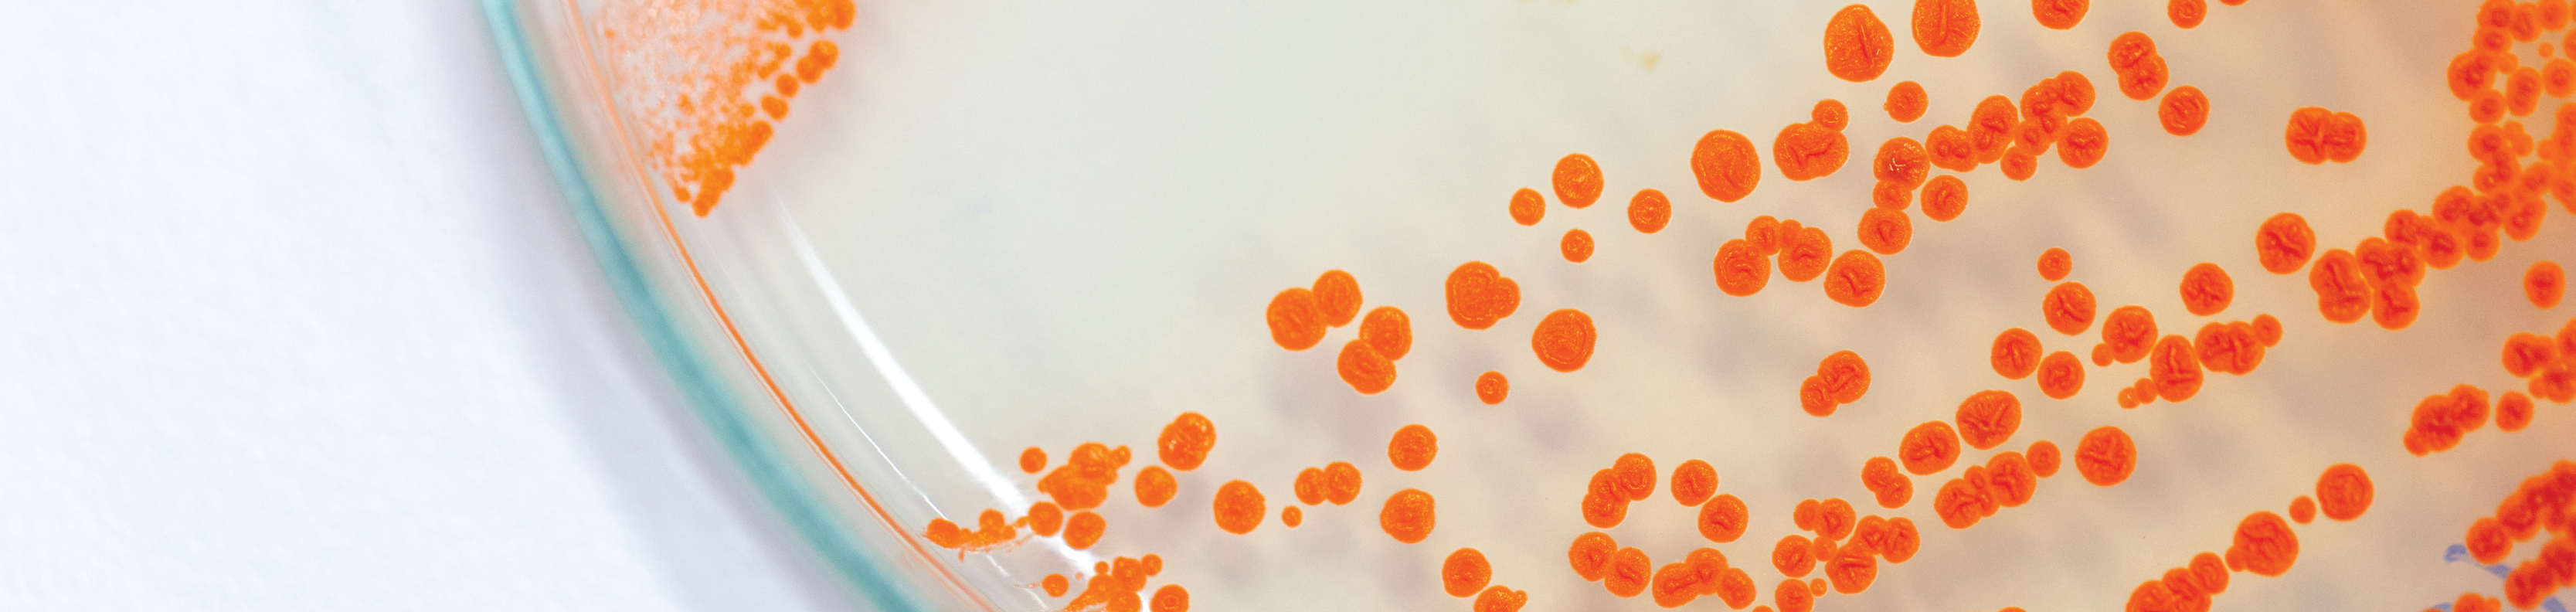

Your partner for food safety testing
Eurofins operates a nationwide network of ISO 17025 accredited food microbiology testing laboratories that supports the food, feed, and dietary supplements industries. We offer a full suite of food safety testing services, including tests for pathogen detection, quality indicator and spoilage organisms, and microbial identification. Our food microbiology labs provide an extensive selection of industry-standard methods, including FDA BAM, AOAC, CMMEF, USP, and USDA MLG. Also, we can support your environmental monitoring program through conventional testing of environmental swabs and sponges for specific microorganisms or a novel approach to risk identification and management - the Enteric Pathogen Risk Indicator (EPRI™) test. Additionally, we can design and execute scientific studies to support your product and process development from method comparisons, challenge studies, and validations through stability studies and shelf-life analyses. Partner with us for fast, accurate, local, and convenient microbiology testing services.
Let us help you find your solution
Pathogen Testing Services
Our ISO 17025 accredited laboratories offer a full suite of pathogen detection tests. We use multiple technology platforms and industry-validated methods.
Common Pathogens:
- Salmonella species
- Listeria monocytogenes and species
- Escherichia coli, E. coli O157:H7, E. coli O157, and STECs
- Staphylococcus aureus
- Campylobacter species
- Bacillus cereus
- Shigella species
- Clostridium perfringens
- Cronobacter sakazakii
- Pseudomonas aeroginosa
Contact us to learn more about our full capabilities!
Indicator & Spoilage Organisms
Our ISO 17025 accredited microbiology laboratories offer an extensive selection of industry-standard methods for indicator and spoilage organisms. We have traditional and rapid methods to suit your needs. We now offer a new approach to pathogen risk identification.
Common Organisms:
- Aerobic Plate Count
- Yeast & Mold
- Coliforms
- Enterobacteriaceae
- Lactic Acid Bacteria
- Alicyclobacillus
- Heterofermentative Lactic Acid Bacteria
- Spore-forming Mesophilic Aerobic Bacteria
- Spore-forming Mesophilic Anaerobic Bacteria
- Spore-forming Thermophilic Aerobic Bacteria
- Osmophilic Yeast & Mold
- Anaerobic Plate Count
- Psychrotropic Plate Count
Contact us to learn more about our full capabilities!
Environmental Monitoring Program Testing Services
Environmental Monitoring is an essential component for microbial control. It is an assessment tool for the effectiveness of your current Food Safety Plan to mitigate the risk of contamination in your manufacturing facility. Our network of ISO 17025 accredited microbiology laboratories is well-positioned to help you each step of the way offering environmental monitoring program testing services that fit your individual needs. With our team of experienced scientists, we look forward to partnering with you, whether you are just getting started, have an established program, or are looking to add further robustness to your current program.
Services We Offer:
- Surface swab and sponge testing
- Air plate testing
- Testing for allergens, pathogens, and indicator organisms
- Listeria strain tracking with Rheonix
- Sampling supplies (air plates, sponges, and swabs)
- Assistance with source tracking through strain identification, serotyping, and genome sequencing
- Consulting services including harborage site investigations
- Training services
Contact us today to get started with your testing needs.
Food Safety Projects
Eurofins advanced microbiology teams are experienced in setting up and executing various food safety and quality determination projects that can be custom designed to your process considerations or unexpected event. Our certified staff display expertise for various processes and food types, providing food and beverage processing authority services that support product and process assessments, validations and deviation analysis, FDA filing assistance and regulatory compliance. Examples of process and product categories we serve include:
- High pressure processing, aseptic processing and packaging, thermal processing such as thermal death time studies, and pasteurization
- Acidified foods, low moisture foods, low water activity foods, low acid foods, and juice
Below are just some of the projects our teams support.
Common Projects Performed:
- Microbial Challenge Studies
- Method Comparisons
- Method Verifications & Validations
- Process Validations
- Spoilage Investigations
- Microbiome Analysis
- Shelf Life Evaluation
Contact us today to inquire about a project specific to your product.
Probiotic Testing Services
We have the expertise and capabilities to individually evaluate each probiotic product and ensure we are preparing the samples for accurate identification, enumeration, or contamination. Our specialized techniques and methods are specifically catered to support your probiotic or microbial product testing needs. We offer testing on both pure strain preparations and multi-strain mixtures in raw materials, finished products, and food products.
Common Services Provided:
- Quantification for label verification of all major probiotic genera, species, and strains
- Eurofins developed proprietary methods for all major probiotic species
- Testing by probiotic manufacturer methods, with over 100 methods available
- Probiotic enumeration by flow cytometry following ISO 19344 Protocol B
- Probiotic identification, both species and strain level, for single strains and blends
- Stability studies to deliver reliable shelf-life data
- Method validation and troubleshooting services
Visit our Probiotics page to read more about our capabilities and services.
Contact us today to get started with your testing needs.
USP Microbiology Testing Services
We offer USP microbiology testing for regulated products like dietary supplements, botanicals, probiotics, and non-sterile products. The methods include a suitability/preparatory test, which serves to verify that the method is appropriate for the product. Our ISO 17025 accredited laboratories offer Microbiological Examination of Nonsterile Products following USP <61>, <62> and Nutritional and Dietary Supplements following <2021>, <2022>.
Services We Offer:
- USP <61> Microbial Enumeration Tests – total aerobic microbial count (TAMC), total yeast and mold count (TYMC)
- USP <62> Tests for Specified Organisms – Bile-Tolerant Gram-Negative (Enterobacteriaceae), Salmonella, P. aeruginosa, S. aureus, C. albicans, E. coli, Clostridium
- USP <2021> Microbial Enumeration Tests – total aerobic microbial count (TAMC), total yeast and mold count (TYMC), Bile-Tolerant Gram-Negative (Enterobacteriaceae)
- USP <2022> Tests for Specified Organisms – Salmonella, S. Aureus, E. coli, Clostridium
- USP <51> Antimicrobial Effectiveness Testing
- USP <60> Microbiological Examination of Nonsterile Products Tests for Burkholderia cepacia Complex
- USP <64> Probiotic Tests
- And more...
Contact us today to learn more about our USP Microbiology service offering.
Virus Testing Services
Virus testing across a variety of matrices to strengthen your surveillance program or aid in investigations for your product or processing environment. Validated by ISO for detecting HAV and NoVG1 and NoVG2 in soft fruits, leaf, stem, and bulb vegetables, bottled water, bivalve molluscan shellfish, as well as on food surfaces.
Contact us to learn more about our full capabilities!
Real-time results
- Quickly access your test results with our simple-to-use online customer portal - Eurofins OnLine (EOL)
- Results are posted within your secure EOL account as each microbiology test is completed
- Access to your data 24/7
- EOL LOGIN
Logistics solutions
- Courier sample pick-up
- Discounted overnight shipping
- On-site module labs
- Unique ExpressMicroTM services
- Microbiology lab locations throughout the United States - find one near you
We are science at your service
- Reliable expertise
- Accurate results
- Transparent process with fast turnaround times
- Nationwide network with unprecedented sample logistics
Fast. Accurate. Local. Convenient. Let's find your solution.